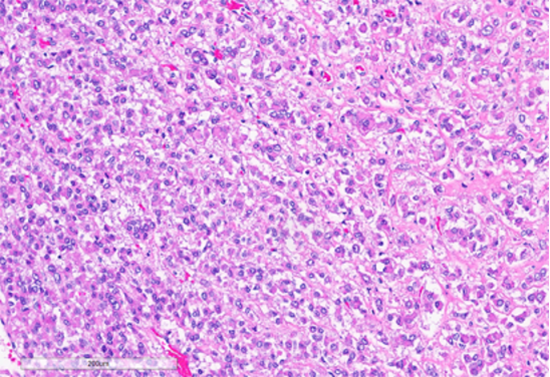
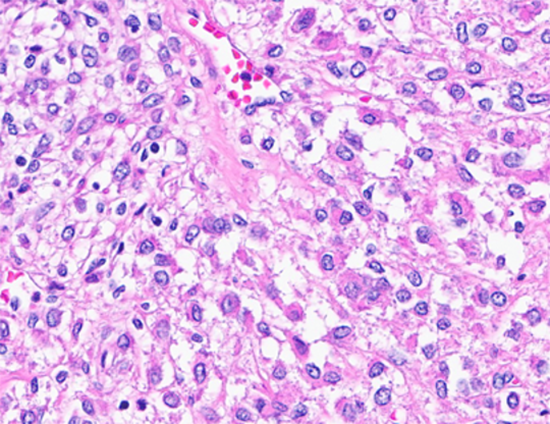
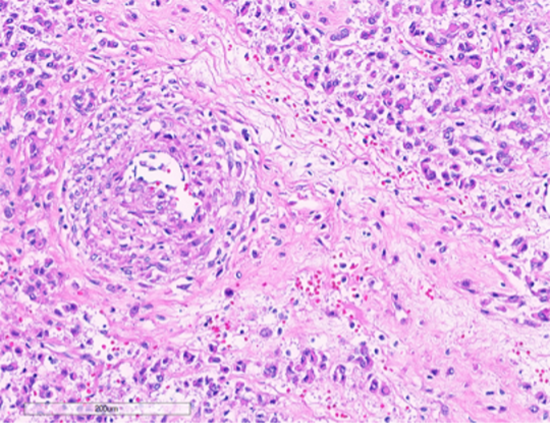

September 2025 Case
History
Woman in her 50’s with abdominal distention, bloating, and vague intermittent left lower quadrant abdominal pain for the past several months. Imaging revealed a heterogeneous, 22.1 cm pelvic mass suspected to arise from the left uterine fundus. Radiologically, it was suggested that this could represent a pedunculated fibroid, with additional differential considerations including smooth muscle tumor of uncertain malignant potential and leiomyosarcoma. Intra-operatively, a 22 cm necrotic mass was noted possibly arising from the left body of the uterus extending to the broad ligament and into the deep posterior cul-de-sac.
Gross Image

Figure 1: Total hysterectomy with bilateral salpingo-oophorectomy specimen showing a large, 22 cm, nodular, tan-brown tumor arising from the broad ligament. (Yellow arrows-tumor, black arrowhead-uterus, green arrow broad ligament)

Figure 2: Cut section of the tumor showing tan-white to brown tumor with areas of hemorrhage and necrosis
Histology
Figure 3: Tumor cells arranged in sheets and vague nests, with predominantly dense eosinophilic cytoplasm. (Hematoxylin and Eosin stained (10x)
Figure 4: Tumor cells with clear cytoplasm. (Hematoxylin and Eosin stained (40x)
Figure 5: Tumor cells intimately associated with blood vessels. (Hematoxylin and Eosin stained (10x)

Figure 6: Foci of tumor with intermediate grade nuclear atypia with occasional multinucleated tumor giant cells (bottom left, black arrow) and bizarre cells with hyperchromatic nuclei (green arrows). (Hematoxylin and Eosin stained (20x)

Figure 7: Section showing areas of tumor cell necrosis (Hematoxylin and Eosin stained (10x)

Figure 8: Tumor cells showing positive staining with desmin (20x)

Figure 9: Tumor cells showing positive staining with HMB45 (20x)
Next generation sequencing results
Cedars Comprehensive Cancer Plus Panel
RESULTS CUMMARY
Biomarker |
VAF |
FDA-approved Therapies |
Off-Label Therapies |
---|---|---|---|
BLM |
28.3% |
No |
No |
TSC2 |
87.1% |
No |
No |
Diagnosis
Perivascular Epithelioid Cell tumor (PEComa) arising in the broad ligament. The tumor is malignant according to the Modified Folpe Criteria and of uncertain malignant potential according to WHO modified gynecology specific criteria. A recent publication reported the modified Folpe criteria to be most accurate in predicting clinical behavior.
Discussion
Perivascular epithelioid cell tumors (PEComas) are rare mesenchymal neoplasms characterized by dual myomelanocytic differentiation. Gynecologic PEComas account for 25% of all PECOmas (1). The broad ligament is an exceptionally uncommon site of origin, accounting for only 2–7% of gynecologic PEComas (2), making this case notable for its unusual location.
The biologic behavior of PEComas has been a subject of ongoing investigation, and multiple classification schemes have been proposed to help stratify risk. The 2020 WHO Classification of Tumors (3) recommends applying the modified gynecologic-specific criteria (4). According to these criteria, features predictive of malignancy include size >5 cm, high-grade nuclear atypia, necrosis, lymphovascular invasion, and mitotic activity >1/50 HPF (4). Our case demonstrates two adverse features—tumor size (22 cm) and necrosis—placing it into the category of PEComa of uncertain malignant potential (UMP).
In contrast, the Modified Folpe criteria (5) assign malignant potential when any one of several adverse features is present. Under this schema, the presence of necrosis alone is sufficient to classify this tumor as malignant PEComa. This highlights an important discrepancy in classification systems, particularly in cases that lie at the borderline of indeterminate and malignant behavior.
Emerging evidence favors the Modified Folpe system as a more accurate predictor of clinical outcome. A recent comparative study (2) of uterine PEComas demonstrated that the Modified Folpe criteria correlated more strongly with relapse and mortality than other proposed schemes. This suggests that, although the WHO criteria offer a gynecologic-focused framework, the Modified Folpe approach may better capture the true malignant potential of PEComas in practice.
Molecular insights
Molecular testing has further clarified the pathogenesis of PEComas. TSC1 and TSC2 mutations are among the most frequently identified alterations, leading to activation of the mTOR signaling pathway. Some tumors have TFE3, RAD51B, or HTR4-ST3GAL1 rearrangements. TSC mutations and TFE3 rearrangements are mutually exclusive. Detection of a TSC2 mutation in this case has both diagnostic and therapeutic implications. From a diagnostic perspective, it provides supportive evidence for classification as a PEComa, as these alterations are considered characteristic of the family of tumors. From a therapeutic standpoint, the identification of TSC2 mutation suggests potential sensitivity to mTOR inhibitors such as everolimus or sirolimus, which have been used in advanced or recurrent PEComas with reported clinical benefit. Although molecular findings are not yet formally incorporated into classification schemes, their integration may become increasingly important in refining prognostication and expanding treatment options for patients.
In summary, this case highlights both the rarity of broad ligament PEComas and the diagnostic challenges posed by differing classification systems. It also underscores the growing role of molecular testing in confirming diagnosis and identifying potential targeted therapies.
Learning points
1. Rare location: Broad ligament is an uncommon site for PEComas (2–7% of gynecologic cases).
2. Classification challenge: WHO criteria (2020) classify this case as PEComa of uncertain malignant potential, whereas Modified Folpe criteria classify it as malignant due to necrosis.
3. Prognostic accuracy: Modified Folpe criteria show stronger correlation with clinical relapse and mortality (PMID: 38905754).
4. Molecular relevance: TSC2 mutations are characteristic of PEComas, support the diagnosis, and may predict response to mTOR inhibitors.
5. Clinical takeaway: Pathologists should clearly communicate classification discrepancies and consider molecular findings when reporting PEComas, as these may guide management decisions.
References
1. Gadducci A, Zannoni GF. Perivascular epithelioid cell tumors (PEComa) of the female genital tract: A challenging question for gynaecologic oncologist and pathologist. Gynecol Oncol Rep. 2020 Jul 6;33:100603. PMID: 32685651.
2. Garzon S, Caliò A, Ferrari FA, et al. Uterine perivascular epithelioid cell tumors (PEComa) and the accuracy of proposed classification systems in predicting the malignant versus non-malignant behavior. Gynecol Oncol. 2024 Sep;188:35-43. PMID: 38905754.
3. WHO Classification of Tumours Editorial Board. Female genital tumours [Internet]. Lyon (France): International Agency for Research on Cancer; 2020 [cited YYYY Mmm D]. (WHO classification of tumours series, 5th ed.; vol. 4). Available from: https://tumourclassification.iarc.who.int/chapters/34.
4. Bennett JA, Braga AC, Pinto A, et al. Uterine PEComas: A Morphologic, Immunohistochemical, and Molecular Analysis of 32 Tumors. Am J Surg Pathol. 2018 Oct;42(10):1370-1383. PMID: 30001237.
5. Conlon N, Soslow RA, Murali R. Perivascular epithelioid tumours (PEComas) of the gynaecological tract. J Clin Pathol. 2015 Jun;68(6):418-26. PMID: 25750268.